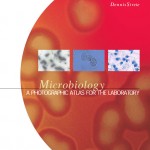
Microbiology book cover

Microbiology
$93.32
| Title | Range | Discount |
|---|---|---|
| Trade Discount | 5 + | 25% |
- Description
- Additional information
Description
Tailored for the introductory microbiology laboratory course, the book features approximately 400 color photographs that demonstrate the results of laboratory procedures and show the morphology of important microorganisms. The photographs demonstrate the unique characteristics of common microorganisms and also their appearance after various stains and tests. Many of the photographs are labeled to point out important structures. The clearly written descriptions accompanying the photos helps students understand and, in some cases, achieve the results depicted in the photographs. The Atlas is appropriate for both majors and non-majors.
1. Microscopes and Their Use in the Study of Cells and Viruses.
2. Microscopic Observation of Bacteria, Fungi, and Protozoa.
3. Staining Bacteria.
4. Cultivation of Bacteria and Fungi.
5. Biochemical Tests for the Identification of Bacteria.
6. Bacterial Identification Methods.
7. Evaluating Antibacterial Chemical Agents.
8. Soil and Water Microbiology.
9. Survey of Microbial Pathogens.
10. Arthropod Vectors of Human Diseases.
11. Multicellular Parasites.
12. Clinical Applications of Host Responses to Infection.
Index.
Tailored for the introductory microbiology laboratory course, the book features approximately 400 color photographs that demonstrate the results of laboratory procedures and show the morphology of important microorganisms. The photographs demonstrate the unique characteristics of common microorganisms and also their appearance after various stains and tests. Many of the photographs are labeled to point out important structures. The clearly written descriptions accompanying the photos helps students understand and, in some cases, achieve the results depicted in the photographs. The Atlas is appropriate for both majors and non-majors.
- Each laboratory procedure has the following sections: a Purpose and Procedure Summary, Tips for Success, and Expected Results. Pg.___
- Comprehensive but concise; easy to use.
- Key terms bolded.
Additional information
| Dimensions | 0.60 × 8.70 × 10.80 in |
|---|---|
| Imprint | |
| Format | |
| ISBN-13 | |
| ISBN-10 | |
| Author | |
| Subjects | science, microbiology, higher education, Applied Sciences, Mixed Majors Microbiology |